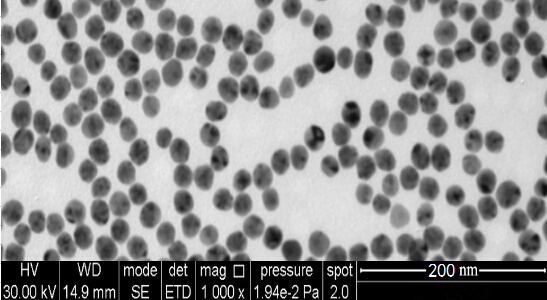
纳米氧化锡锑

纳米氧化锡锑 新品
Antimony tin oxide
128221-48-7
128221-48-7
¥450
1袋
起订
上海 更新日期:2025-09-16
产品详情:
- 中文名称:
- 氧化锡锑
- 英文名称:
- Antimony tin oxide
- CAS号:
- 128221-48-7
- 保存条件:
- 密封保存于干燥、阴凉的环境中
- 纯度规格:
- 99.9-99.999%
- 产品类别:
- 氧化物 氧化锑锡
- 颜色/外观:
- 淡蓝色
公司简介
上海肖晃纳米科技有限公司,主要是一家从事各类金属粉末与非金属单质粉体、超细金属粉末、超细合金粉末、超细碳化物粉末、超细氮化物粉末、氧化物粉体、碳化物粉体、氮化物粉体以及其它化合物粉体和特殊功能粉体的研究、开发、销售于一体的高科技企业。
肖晃自成立以来十分注重于科技创新和人才培养,与全国多所高校、研究所都有技术合作与支持;公司汇集业内专业精英和优秀的管理团队,专注于各类纳米材料的研发和制造。公司自主生产的产品多达100多种,产品远销亚、欧、美多个国家和地区。
公司秉承“专业、创新、务实、诚信”的经营理念,坚持“以质量求生存、以质量求发展、向质量要效益,用户是企业发展的源泉”的企业宗旨。公司立足国内高校、研究所、科研单位、高新企业。产品满足国内市场的同时,积极拓展海外市场,营销网络正逐步向欧亚及南北美洲等国家和地区市场延伸,力使公司的国际竞争力得到进一步提升,打造知名国际品牌。
公司类型:公司主要从事各类金属与非金属单质粉体、氧化物粉体、碳化物粉体、氮化物粉体以及其他化合物粉体和特殊功能粉体的研发、生产、销售于一体的高科技企业。
| 成立日期 | (10年) |
| 注册资本 | 500万人民币 |
| 员工人数 | 50-100人 |
| 年营业额 | ¥ 500万-1000万 |
| 经营模式 | 工厂,试剂,定制,服务 |
| 主营行业 | 无机化工,化学试剂,无机化合物,单质元素,高纯试剂 |
氧化锡锑相关厂家报价 更多
-

- 掺锑二氧化锡;纳米ATO;氧化锑锡
- 浙江亚美纳米科技有限公司 VIP
- 2026-04-13
- ¥580
-

- 纳米ATO 纳米级氧化锡锑导电剂导电薄膜添加
- 达西浓纳米科技(常州)有限公司
- 2026-04-13
- 询价
-

- 氧化锡锑 128221-48-7 锑锡氧化物 用于抗静电涂料
- 湖北鑫杰成化工科技有限公司 VIP
- 2026-04-13
- ¥200
-

- ATO纳米导电粉 抗静电氧化锡锑 10nm纳米氧化锡锑
- 上海联田材料科技有限公司 VIP
- 2026-04-12
- 询价
-

- 纳米透明导电氧化锡锑,超细氧化锡锑ATO,10-15nm高纯氧化锡锑
- 宁波罗飞纳米科技有限公司 VIP
- 2026-04-11
- ¥400
-

- ATO溶液,氧化锡锑粉体纳米分散液
- 上海沪正纳米科技有限公司
- 2026-04-10
- 询价
-

- 氧化锡锑分散液
- 雨木(宁波)新材料有限公司 VIP
- 2026-03-31
- 询价
-

- Antimony Tin Oxide (ATO) or Antimony-doped Tin Oxide
- 湖南科莱新材料有限公司
- 2026-02-04
- ¥90
-

- 掺锑二氧化锡
- 上海先芯新材料科技有限公司 VIP
- 2026-01-05
- 询价
-

- 纳米氧化锡锑粉末 纳米(ATO)粉末材料 ATO粉末材料 镭雕粉
- 湖南昱烯瓴新材料有限公司
- 2025-10-12
- ¥342